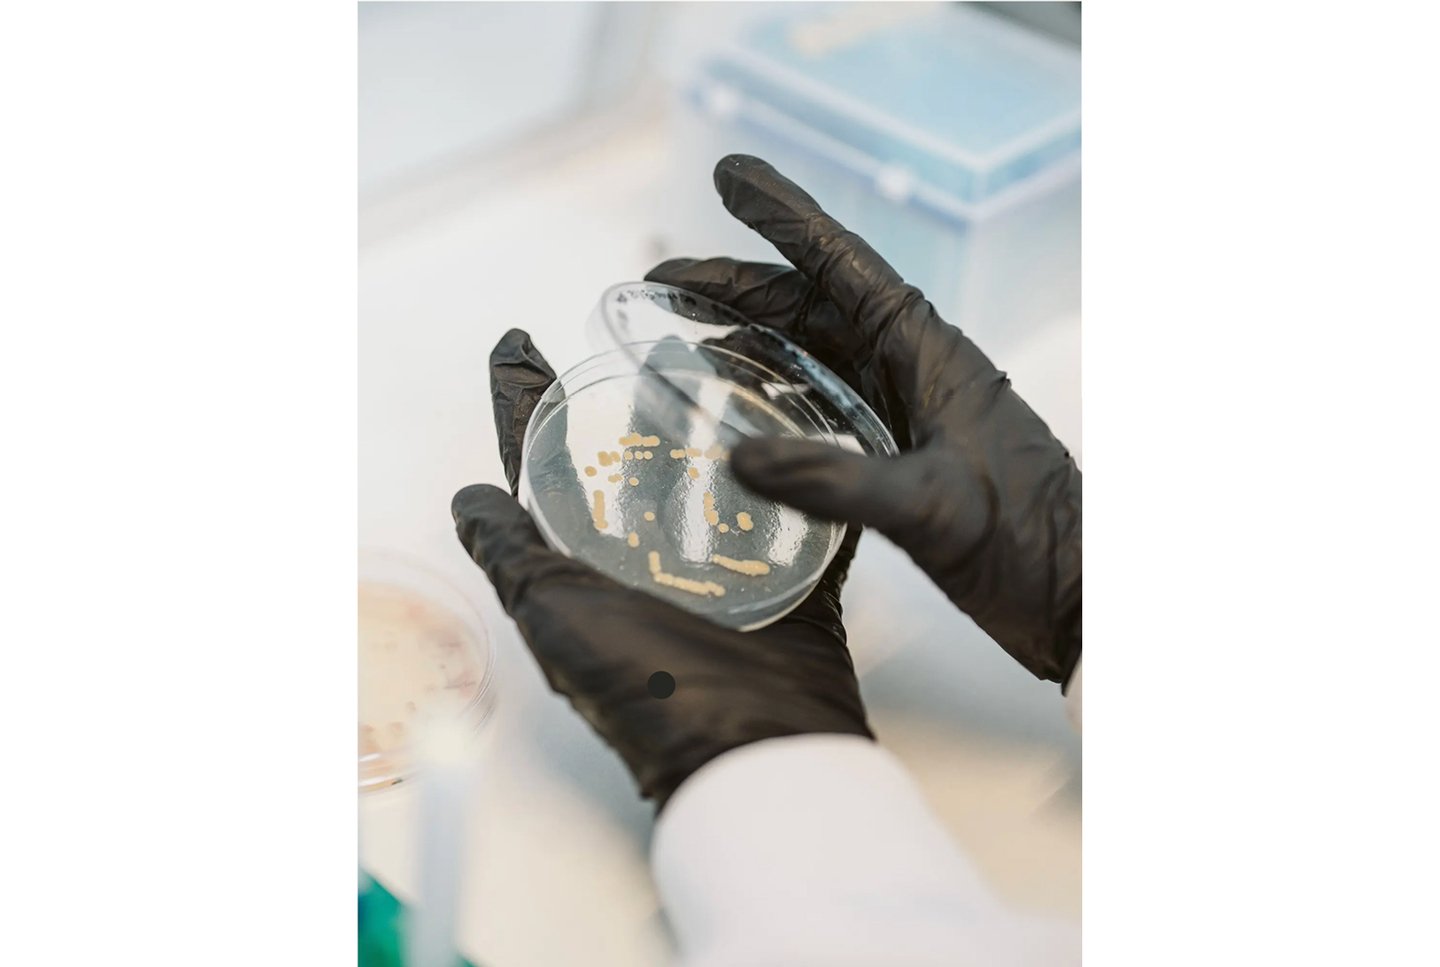

Исследование онтологии современного экологичного дизайна
Рубрикатор
1. Введение 2. Глава 1. Экология как совместность: процессуальный дизайн и материал как партнёр 2.1 Triplex Stool, Studio Ryte (2020) 2.2 Modern Synthesis — «Grow Textiles from Microbes» (2022) 2.3 Algae Plastic Chair, Klarenbeek & Dros (2019) 2.4The Mycelium Project — Print and Grow (2020) 2.5 Full Grown — выращенная мебель (Гэвин Манро, Великобритания, 2010–наст. вр.) 3. Глава 2. Реди-мейд и повторное использование: дизайн, который работает с уже существующим миром 3.1 Братья Кампана: способ показать избыток 3.2 Мартино Гампер: реанимация типовых стульев 4. Глава 3. Переработка как новая эстетика: цифровые технологии, отходы и постэкологичный дизайн 4.1 Eburet: 3D-печать из переработанного полистирола 4.2 Прессованная мебель из переработанного пластика Dirk van der Kooij 5. Вывод 6. Источники
Введение
Современный дизайн все чаще сталкивается с вопросами, которые раньше считались делом экологов или технологов. Обсуждение устойчивости вошло в практику мебельных брендов, экспериментальных студий, ремесленных лабораторий и цифровых фабрик. Дизайнеры работают с биоразлагаемыми материалами, осваивают переработанный пластик, создают вещи из найденных предметов и соединяют ручные техники с роботизированным производством. При этом каждый объект демонстрирует не только новую технику или свежий визуальный язык. Он выражает определенное представление о том, как человек соотносится с окружающим миром и каким может быть будущее материальной культуры.
В этой работе я рассматриваю экологичный дизайн с опорой на философские тексты. Я выбрала такой подход, потому что именно философия позволяет увидеть глубинные установки, которые стоят за решениями дизайнеров. Когда объект создают из грибного мицелия, из переработанных бутылок или из промышленных отходов, речь идет не только о технической возможности. Формируется определенная логика отношений между человеком, природой, технологией и отходами. Она обычно остается скрытой, если ограничиться анализом формы. Постгуманистические подходы помогают эту скрытую логику рассмотреть.
Работы философов Эндрю Пикеринга, Донны Харауэй и Тимоти Мортона дают возможность увидеть дизайн не как последовательность команд, направленных к материалу, а как процесс совместного действия. В этих концепциях человек не занимает центральное положение, а становится одним из участников сети, где действуют материалы, организмы, инструменты и технологические процессы. Такой взгляд помогает объяснить, почему в современном экодизайне появляются несколько противоположных направлений. Одни студии стремятся к прозрачности и сдержанности, подчеркивая природность материалов и их минимальную обработку. Другие выбирают стратегию избыточности, создают вещи из отходов и поднимают тему перепроизводства через визуальное усиление следов потребления.
Мне важно проследить, как эти разные установки проявляются в реальных предметах. Именно поэтому исследование опирается не только на теорию, но и на визуальный анализ. В качестве материала взяты проекты, выполненные с применением переработанных или природных материалов, а также работы, построенные на эстетике мусора и вторичных пластов. Выборка позволяет увидеть диапазон подходов к устойчивости и понять, какие идеи лежат в их основе.
Гипотеза: различные онтологии отношения человека к природе порождают отличающиеся визуальные стратегии экологичного дизайна. Способ понимания природы — как управляемого ресурса, взаимодействующего актора или источника экологической тревожности — определяет выбор материала, характер формы и выраженность сдержанности или избыточности в объекте, что позволяет выявить связь между онтологическим основанием и эстетикой предметного дизайна.
Глава 1. Экология как совместность: процессуальный дизайн и материал как партнёр
В современном предметном дизайне одним из самых заметных направлений экологичности стала работа с материалом как с самостоятельным участником процесса. В этой логике дизайнер перестаёт мыслить вещь как результат полного контроля, а видит её как форму, возникающую из взаимодействия человека, среды и поведения самого вещества. Это смещение хорошо заметно на уровне визуального языка: поверхности становятся пористыми, органичными, непредсказуемыми; контуры меньше напоминают строгие геометрические схемы и больше — следы роста, высыхания, спрессовывания или распада.
Такой подход часто описывают как процессуальный дизайн, где материал не подчиняется заранее составленному плану, а «ведёт» проект своим поведением. Именно это Пикеринг называет «танцем человека и материала» — процессом, в котором оба участника постоянно реагируют друг на друга [Пикеринг, 2020, с. 15–18]. В его модели природа перестаёт быть пассивной материей, пригодной только для обработки, и становится актором, на которого нужно настроиться.
В предметном дизайне этот взгляд проявляется в том, что экологичность рассматривается не как количественное потребление или процент переработки, а как тип отношений между дизайнером и материалом. Не столько «какой материал», сколько «каким образом» с ним работают. Мицелий, водоросли, бактериальная целлюлоза или органические композиции становятся не просто альтернативами пластику, но и средствами выстраивания новой формы совместности с природой.
Triplex Stool, Studio Ryte (2020)
Triplex Stool, Studio Ryte (2020). Табурет из льняного композита, собранный из послойно уложенных волокон с биосмолой.
Стул Triplex Stool студии Studio Ryte — хороший пример того, как дизайнеры работают с природным материалом не через подавление, а через сотрудничество. В основе конструкции используется льняное волокно, которое накладывают слоями и пропитывают био-смолой, создавая прочный композит без участия синтетического пластика.
Triplex Stool, Studio Ryte (2020). Табурет из льняного композита, собранный из послойно уложенных волокон с биосмолой.
Modern Synthesis — «Grow Textiles from Microbes» (2022)
Процесс создания нового класса биоматериалов, призванного заменить кожу животных и синтетические ткани на основе пластика.
Компания использует бактерии, которые превращают сельскохозяйственные сахара и побочные продукты переработки в наноцеллюлозу, а затем «ткают» из неё текстиль.
В основе метода — живая биоткань: бактерии растут на текстильном каркасе, создавая волокнистую структуру, которую можно использовать как натуральную, био-деградируемую ткань.
Микрокрафт Новый взгляд на текстильное ремесло, начиная с наномасштаба
Algae Plastic Chair, Klarenbeek & Dros (2019)
Algae Egg Chair — Klarenbeek Dros, fully biobased remake of the Garden Egg Chair
Пластик из водорослей сам задаёт цветовые нюансы и текстуру. Невозможно заранее определить, как распределятся пигменты или как поведёт себя масса при отливке. Эта непредсказуемость подчеркивается, и форма становится документом происходящего процесса.
The Mycelium Project — Print and Grow (2020)
Объект из мицелия. Mycelium
В этом проекте стул не формуют традиционным способом — его печатают каркас на 3D-принтере, а затем заселяют мицелием, который постепенно заполняет структуру и превращает её в устойчивый объём. Здесь дизайнер буквально отходит от роли «создателя формы» и становится тем, кто задаёт условия, не сам результат.
Поверхность стула всегда различается: где-то мицелий разрастается плотнее, где-то остаётся более рыхлым, создавая тонкие перепады и пористые участки. Эти «несовпадения» не исправляются, потому что они — часть идеи. Технологический след (слои печати) соединяется с биологическим следом (структура мицелия), и объект становится документом взаимодействия материалов, а не итогом контроля.
Объект из мицелия. Mycelium
Стул «Mycelium»
Процесс производства мебели из мицения
Важно отметить, что такие объекты отличает не только их материал, но и новая логика визуальной выразительности. В ремесле и модернизме долгие десятилетия ценились гладкость, целостность и отсутствие следов вмешательства. Экологичность, напротив, привносит ценность «следу»: неровности и несовершенства становятся знаком того, что материал участвовал в создании формы.
Этот принцип вписывается в тезис Пикеринга о том, что экологичность может проявляться как уважение к агентности материального мира, как отказ от полного контроля и готовность к непредвиденному [Пикеринг, 2020]. В дизайне это превращается в особую эстетику — мягкую, органичную, иногда даже «несобранную», но всегда честную по отношению к происхождению объекта.
У процессуального дизайна есть и исторические корни. Он наследует часть идей модернизма — прежде всего, стремление к честности материала, но радикально переосмысливает эту «честность». Если модернист скрывал любую случайность ради идеала, то дизайнер XXI века делает случайность видимой частью образа. Это уже не рациональная прозрачность, а экологичная открытость: объект демонстрирует, что он рождается не из проекта, а из отношения.
Full Grown — выращенная мебель (Гэвин Манро, Великобритания, 2010–наст. вр.)
Full Grown — Dietel Chair (2018)
Проект Full Grown выводит идею совместности на новый уровень, показывая, что экологичный объект может не просто «делаться» из природного материала, а вырастать как живой организм. Гэвин Манро формирует стулья, зеркала и светильники, направляя рост деревьев так, чтобы каждая ветвь становилась будущей деталью конструкции. Вместе со своими работами диайнер сопровоживает процесс роста, а среда (почва, климат, сезонность) становится таким же участником проектирования, как и человек. Форма получается не через сборку, а через годы биологического развития, и на ней остаются следы природного времени: утолщения коры, изгибы от ветра, различная плотность слоёв.
Конструкция для создания формы стула
В первом направлении экологичного дизайна материал рассматривается как партнёр. Дизайнер действует не как авторитарный создатель формы, а как участник процесса, который ведёт диалог с веществом. Эта позиция опирается на процессуальную онтологию Пикеринга, где человек и материал равноправно участвуют в «танце» взаимодействия [Пикеринг, 2020].
Визуально такие объекты отличаются органичностью, вариативностью и честностью поверхности. Их эстетика становится доказательством того, что экологичность формируется в отношениях, а не в количестве переработанных килограммов. Именно эта совместность — первая онтология экологичного дизайна.
Глава 2. Реди-мейд и повторное использование: дизайн, который работает с уже существующим миром
Экологичный дизайн нередко представляют через инновации, биоматериалы, 3D-печать, лабораторные эксперименты. Но прежде чем появились новые технологии, в дизайне уже существовала тихая, почти аскетичная стратегия, основанная на уважении к тому, что уже произведено. Это реди-мейд-подход: работа не с «чистым» сырьём, а с предметами, которые прожили свою жизнь, потеряли функцию, вышли из моды или просто перестали быть нужными.
Тут материал — это уже не только древесина, пластик или металл как абстрактные категории. Материал — это бывший стул, выкинутая табуретка, труба, фанерная панель, дверная ручка. То есть объекты со своей биографией, с накопленными следами использования и с той энергией труда, которую в них вложили раньше.
Circle of Chairs — работа Ай Вэйвэя, созданная из старых китайских табуретов. Объект собран из множества найденных вещей и превращён в замкнутую конструкцию
Именно здесь начинается первый важный онтологический сдвиг. В классическом индустриальном дизайне материал рассматривался как нейтральный ресурс, который нужно «правильно обработать». В стратегии реди-мейда дизайнер работает не с ресурсом, а с агентом, который уже что-то сделал в мире. Он вступает в диалог с вещью, а не заставляет вещь подчиниться заранее придуманной форме.
Эта логика удивительным образом перекликается с Пикерингом и его идеей «оркестровки взаимодействий» между человеком и не-человеческими акторами, где процесс — это не навязывание формы, а настройка, прислушивание, согласование [Pickering, 2017]. Реди-мейд оказывается практической формой такого отношения: дизайнер не подавляет материал, а договаривается с ним, сохраняя его несовершенства, историю, странности.
Bicycle Wheel — Марсель Дюшан, 1913. Один из первых реди-мейдов, где художник соединяет колесо велосипеда и табурет, лишая оба предмета привычной функции
Наконец, реди-мейд работает и на уровне критики потребления. Он визуализирует не абстрактные принципы устойчивости, а конкретные последствия перепроизводства, когда новых вещей слишком много, а старые не успевают исчезнуть. Вместо того чтобы создавать ещё один объект, дизайнер делает видимым уже накопившийся объём предметов. Это не столько «зелёная» эстетика, сколько способ показать реальность через материальные остатки.
Братья Кампана: способ показать избыток
Favela Chair — братья Кампана, 1991
Если смотреть на кресла братьев Кампана как на одну большую серию, становится видно, как радикально они переосмысливают «вторичные» материалы. Кресло Favela собрано из обрезков сосновых реек, которые буквально нашпиливают объём сиденья; здесь нет скрытого каркаса, вся конструкция — открытая куча «строительного мусора», удерживаемая только гвоздями и гравитацией.
Vermelha Chair — братья Кампана, 1998
В Vermelha сотни метров красного шнура опутывают металлический каркас так плотно, что предмет превращается в клубок, который будто бы продолжает расти за пределы своей функции.
В серии Banquete на стальной основе собираются десятки плюшевых игрушек: мягкие звери облепляют кресло плотным слоем, и уже непонятно, сидим ли мы на мебели или на свалке детских вещей.
Серии Banquete от братьев Кампана
Визуально все эти предметы работают одинаково: они не маскируют перепроизводство, а выставляют его напоказ. В Favela виден каждый обрезок, в Banquete различим каждый плюшевый «персонаж», в Vermelha считывается жест длительного, почти навязчивого плетения. Это не аккуратный «зелёный» дизайн, который успокаивает пользователя, а скорее дизайн, который честно показывает, из чего сделан уют: из избытка древесины, пластика, текстиля, фабричных отходов и забытых игрушек. Такой подход хорошо ложится на идею «тёмной экологии» Мортона, где экологичность не означает очищенную картинку, а требует признать, что мы живём среди липких, чрезмерных, иногда пугающе живых связей между вещами, отходами и живыми существами [Мортон, 2019].
Мартино Гампер: реанимация типовых стульев
100 Chairs in 100 Days
Проект 100 Chairs in 100 Days Мартино Гампера работает с совершенно другой логикой избыточности. Дизайнер собирает на блошиных рынках и свалках старые стулья, разбирает их и собирает заново, комбинируя спинки, ножки и сиденья так, что каждый новый объект становится коллажем из предыдущих жизней.
100 Chairs in 100 Days. Выставочное пространство
На выставочных фото видно, как в одном стуле соседствуют пластиковая спинка от офисного кресла и деревянное сиденье из школьной мебели, в другом — сразу несколько каркасов, «насаженных» друг на друга. Получается поле из сотни разомкнутых типологий: стандартный стул перестает быть невидимым фоном и вдруг оказывается носителем длинной истории использования.
Визуально эти стулья выглядят странно и немного нелепо: у них нарушены пропорции, линии ломаются, стыки подчеркнуты, а не спрятаны. Но именно через эту нелепость считывается принцип, о котором пишет Пикеринг, когда говорит о «танце агента и материала» [Пикеринг, 2017]. Дизайнер не просто навязывает форму сверху. Он вступает в переговоры с тем, что уже есть: с найденными предметами, их повреждениями, стандартами производства, следами эксплуатации. В каждом стуле виден момент, где человеческое решение сталкивается с упрямством материала: куда встанет лишняя ножка, как поведёт себя пластиковая спинка, насколько далеко можно увести исходную типологию и всё ещё сохранить возможность сидеть.
100 Chairs in 100 Days
Если сравнивать Гампера и братьев Кампана, хорошо видно, как по-разному они работают с темой перепотребления. Кампана максимизируют материальный шум, собирая излишки в барочные объекты, где глаз цепляется за тысячи деталей. Гампер, наоборот, раскладывает избыток по слоям и показывает его как набор конкретных, уже существующих форм. У него избыточность стала не столько «мусорной плотью» современного мира, сколько плотность биографий, накопившихся в предметах.
Глава 3. Переработка как новая эстетика: цифровые технологии, отходы и постэкологичный дизайн
Современная переработка пластика давно перестала быть только технологией утилизации. В дизайне она превращается в метод формообразования, где материал диктует свои правила, а дизайнер учится работать не с «чистым» сырьём, а с тем, что уже прошло длинную потребительскую биографию. Если раньше переработка воспринималась как невидимый процесс, происходящий «где-то на заводе», то сейчас она выходит на поверхность предмета. Форма становится честной: она не скрывает происхождение материала, а подчеркивает его структуру, историю и следы переработки.
Стул Chubby
Такой подход близок к логике, которую описывает Тимоти Мортон, говоря о «тёмной экологии» и необходимости видеть красоту в том, что прежде считалось неэстетичным [Morton, 2016]. Здесь отход перестаёт быть «чужим», а становится частью общей сети — он становится тем самым актором, про которого писал Пикеринг, формируя свою собственную линию поведения внутри дизайнерского процесса [Pickering, 2017]. Материал больше не подчиняется, а вступает в совместную игру, где дизайнер лишь один из участников.
Eburet: 3D-печать из переработанного полистирола
Хороший пример такой эстетики — мебель студии Eburet, напечатанная на крупноформатных 3D-принтерах из переработанного полистирола и ПВХ, собранных из остатков пищевой промышленности и старых надувных лодок.
Основательница бренда Eburet Ольга Найденова
Столик фирмы Eburet
Поверхность предметов намеренно не шлифуется: видны характерные полосы слоями, небольшие комки и гранулы, ритм экструзии. В креслах и табуретах Eburet пластик ведёт себя как вязкая, живая субстанция: он не стремится быть похожим на дерево или металл, а демонстрирует собственную материальность.
Кресло MARINA LOUNGE
Это и есть тот момент, когда вещь перестаёт быть «вторичной» и становится самостоятельным визуальным высказыванием. Дизайнер здесь только задаёт траекторию, а материал завершает форму.
Архивные фото бренда
Цифровые технологии переработки меняют сам принцип создания мебели. В отличие от традиционного ремесла, где материал подгоняют под заранее заданную форму, в цифровой переработке материал ведёт себя по-своему, и дизайнер вынужден учитывать его текучесть, вязкость, температуру, время застывания. Форма получается результатом динамической системы взаимодействий.
Прессованная мебель из переработанного пластика Dirk van der Kooij
Работы Дирка ван дер Куйя — ещё один яркий пример. Его стул Endless печатается из переработанного ABS-пластика, плавленного в длинную мононить, которая затем наматывается в объём. Линия печати становится не скрываемой, а ключевой визуальной характеристикой. Стул будто построен из одного непрерывного жеста.
Стул Endless
У van der Kooij есть и другие работы (например, серию, обычно упоминаемую как Menhir Chair), которые играют на грани скульптуры, арт-объекта и мебели. Несмотря на то, что многие из них не нацелены на массовое производство, они задают вопросы о том, что мы считаем «мебелью», и какую роль могут играть переработанные материалы и цифровые технологии в формировании новых визуальных и функциональных архетипов.
Эти объекты демонстрируют, что переработка и цифровые технологии — не просто методы экономии ресурсов, но инструменты художественного высказывания. Они показывают, что устойчивый дизайн может быть не прагматичным и утилитарным, а экспериментальным и даже провокационным.
Стол Meltingpot
Стол Meltingpot
Миска Wandel
Важная особенность современной переработки заключается в том, что она перестаёт быть утилитарным этапом и становится эстетической платформой. Многие дизайнеры специально оставляют на поверхности вещи «шумы», градиенты, разноцветные включения, мелкие дефекты, которые образуются при переплавке. Эта визуальная стратегия работает как манифест: материал не скрывает, что он пережил несколько жизней. Это честный разговор о перепроизводстве, где переработка становится новым языком.
Вывод
Исследование показывает, что экологичный дизайн сегодня развивается сразу в нескольких направлениях, и каждое из них создаёт свой визуальный язык через работу с материалом.
В проектах, основанных на природных материалах и бережном производстве, форма получается чистой, спокойной и предсказуемой. Здесь устойчивость понимается как минимальное вмешательство, поэтому визуальная пластика опирается на естественные свойства материала.
В реди-мейде и пересборке акцент смещается на биографию предметов: переработанные детали, несовпадения и следы прежней жизни становятся частью образа. Это рождает плотную, составную эстетику, где материал не скрыт, а подчеркнут.
Третье направление — технологическая переработка: 3D-печать, прессованные плиты, цифровая работа с отходами. Здесь форму диктует само поведение вторичного сырья: ритм слоёв, включения, текучесть расплава. Такой дизайн использует непредсказуемость материала как источник визуальной выразительности.
В итоге исследование подтверждает: различия в эстетике устойчивой мебели объясняются не стилем, а тем, как дизайнер взаимодействует с материалом. Именно выбранная модель работы — бережное использование, пересборка или цифровая переработка — определяет характер формы, текстуры и итоговый образ экологичного предмета.
Бард К. Агентный реализм // Опыты нечеловеческого гостеприимства / Саркисов К., Крамар М. (сост.). М.: V-A-C Press, 2018. С. 42–121.
Мортон Т. Стать экологичным. М.: Ад Маргинем Пресс, 2022.
Пикеринг Э. Новые онтологии. М.: Изд. дом Высшей школы экономики, 2020.
Харауэй Д. Тентакулярное мышление // Логос. 2020. № 1. С. 27–56.
Археология периферии / Григорян Ю. (ред.). М.: Московский урбанистический форум, 2013.
Studio Ryte releases Triplex Stool made from flax fibre and bio-resin // Dezeen. 06.10.2020. URL: https://www.dezeen.com/2020/10/06/triplex-stool-studio-ryte-flax-fibre/ (дата обращения: 15.11.2025).
Modern Synthesis. Официальный сайт студии. URL: https://www.modernsynthesis.com/ (дата обращения: 21.11.2025).
Dotunusual». Официальный сайт бренда / студии. URL: https://www.dotunusual.com/ дата обращения: 20.11.2025).
Full Grown — Dietel Chair (2018) // MADparis.fr. URL: https://madparis.fr/Full-Grown-Dietel-Chair-2018 (дата обращения: 18.11.2025).
Реди-мейд в искусстве // Artmot.ru. URL: https://artmot.ru/redi-meyd-v-iskusstve/ (дата обращения: 27.11.2025).
Favela Chair, 1991 // Campana Brothers. URL: https://www.campanabrothers.com/favela-chair (дата обращения: 23.11.2025).
Martino Gamper — work «Chairs / 100 Chairs in 100 Days» // The Modern Institute. URL: https://www.themoderninstitute.com/artists/martino-gamper/works/chairs/154/ (дата обращения: 23.11.2025).
Eburet. URL: https://eburet.com/ (дата обращения: 19.11.2025).
Chubby Chair // Kooij Studio. URL: https://kooij.com/chubby (дата обращения: 27.11.2025).